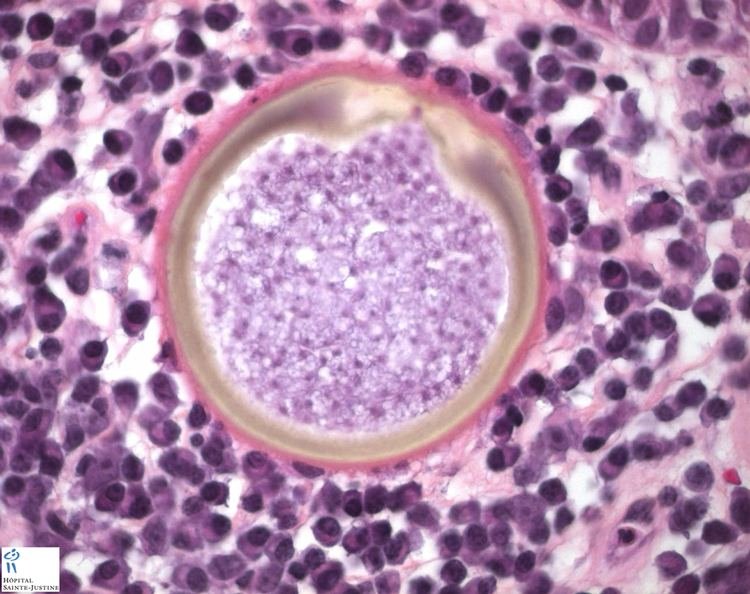

Source- textbook of dental materials manapalil
Author: Gerlyn Braganza
Mouth cancer








Source – Mayo clinic
Glass ionomer cements






Types of bacterial cell wall



Source- textbook of microbiology for dental students c p baveja
Talon cusp



Source- textbook of oral pathology Shafers and Google images
Dilaceration



Since dilacerated teeth frequently present difficult problems during endodontic therapy and at the time of extraction if the operator is unaware of the condition, the need for preoperative radiographs before any such procedures are carried out is self-evident.
Source- textbook of oral pathology Shafers and Google images
Concresence


Source- textbook of oral pathology Shafers and Google images
Rhinosporidiosis
(i) Rhinosporidiosis is a chronic granulomatous disease characterised by formation of friable polyps, usually confined to the nose, mouth or eye.

(i) Causative agent is Rhinosporidium seeberi.
(iii) More than 80% cases are reported in India and Sri Lanka.
(iv) The mode of infection is not known but most infections occur in males who have frequent contact with stagnant water or aquatic life.
ORAL MANIFESTATIONS
•Oronasopharyngeal lesions appear as soft red polypoid growth which spread to pharynx and larynx.
• These lesions often contain mucoid discharge and are vascular.
LAB DIAGNOSIS
• The fungus has not been cultivated.
• Diagnosis depends on the demonstration of sporangia
•Tissue sections stained with H & E stain show large number of endospores within the sporangia embedded in a stroma of connective tissue and capillaries.
The sporangium (10-200 um) contains thousands of endospores (6-7 µm in diameter)


Source – textbook of microbiology for dental students c p baveja and Google images
Bisphosphonates
Bisphosphonates are first-line drugs used to treat a wide range of bone disorders, including:
- Osteoporotic fragility fractures
- Paget’s disease of bone
- Certain cancers – where they are used to prevent pathological fractures
Bisphosphonates are easily identifiable drugs, too. They all contain either of the following two suffixes – –dronate or –dronic acid.

Mechanism of Action
Bisphosphonates act on bone – where they inhibit cells called osteoclasts.
The function of osteoclasts is to break down bone, an essential function for the bone maintenance and repair. However, in diseases such as osteoporosis, osteoclasts can play a pathological role and so, by intervening in how osteoclasts work, it can reduce bone loss and improve bone mass.
Bisphosphonates have a similar structure to naturally occurring pyrophosphate and so are readily absorbed into bone. There, bisphosphonates accumulate in osteoclast cells – triggering cell death. Fewer osteoclast cells lead to reduced bone turnover and an increase in bone mass and reduction in bone loss.
Side Effects
One of the most common side effects of orally administered bisphosphonates is esophagitis – or inflammation of the esophagus. To reduce the risk of esophagitis, patients are counseled to take bisphosphonates in a more cautionary manner compared to other drug classes.
Patients are counselled to take these drugs whilst remaining upright, first thing in the morning and 30 minutes before food/medicines and taken with a full glass of water. Patients should remain upright for 30-minutes post-administration. By taking these steps, the risk of esophagitis or irritation to the esophagus, is substantially reduced.
Other side effects of bisphosphonates include:
- Hypophosphatemia – low blood phosphorus levels
- Osteonecrosis of the jaw – a rare effect associated with high-dose IV therapy
- Atypical femoral fracture
- Headache
- Constipation
- Nausea
Bisphosphonates may also be associated with other side effects not listed in this guide.
Source – PTCB guide to pharmacology
Mediators of inflammation


Source- textbook of pathology for dental students Ramdas Nayak and pinterest





